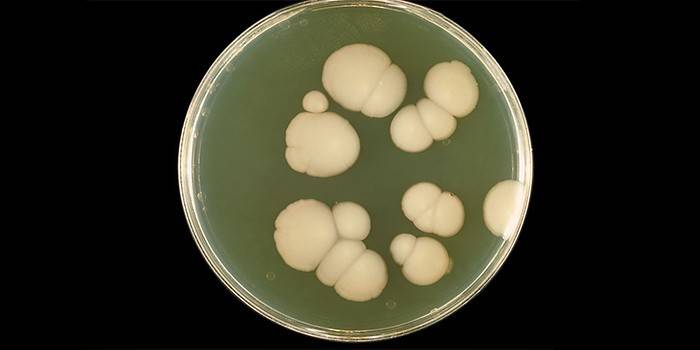

Flucostat para homens: instruções de uso da droga
Com infecções fúngicas (micoses) da pele, distúrbios da microflora e disbiose, o Flucostat é prescrito para homens. A droga é prejudicial para fungos Candida e outros patógenos de infecções fúngicas. Em caso de desordens imunes, Flucostat prescreve-se para a prevenção de candidiasis de uma natureza sistemática e local na pele, membranas mucosas.
Flucostat para homens
Flucostat é uma droga que pertence ao grupo de drogas antifúngicas de amplo espectro. A medicação é ativa para os microrganismos Candida spp., Cryptococcus neoformans, Microsporum spp., Trichoptyton spp. E Histoplasma capsulatum. Flucostat de homens do tordo prescreve-se se houver sinais de candidiasis de natureza sistêmica ou local (o fungo localiza-se, por via de regra, nos genitals).
Composição e forma de lançamento
A droga está disponível na forma de cápsulas, comprimidos e soluções. A diversidade farmacêutica é devida à necessidade de atuar de maneira abrangente nas áreas afetadas pelo fungo. A composição do medicamento depende da forma de liberação do medicamento. A tabela mostra as principais formas da droga, seus componentes principais e adicionais.
|
Forma de liberação |
Componente ativo |
Excipientes |
|---|---|---|
|
Comprimidos |
50 ou 100 mg de fluconazol |
Amido de batata, sacarose, sulfato de sódio. |
|
Cápsulas |
50 mg de fluconazol |
Lactose, amido de batata, dióxido de silício, estearato de magnésio, sulfato de sódio. |
|
Solução para administração intravenosa |
Fluconazol 2 mg |
Cloreto de sódio; água esterilizada para injeção. |

O mecanismo de ação da droga
O medicamento tem um efeito prejudicial nos fungos, destrói sua parede celular ao danificar a estrutura das proteínas.Após a ingestão de comprimidos ou cápsulas, o medicamento é bem absorvido no intestino delgado. A biodisponibilidade do componente ativo principal é de cerca de 90%. A concentração máxima de fluconazol no plasma sanguíneo após uma dose de jejum de 150 mg é de aproximadamente 80%. A substância activa penetra facilmente em todos os fluidos biológicos (sangue, urina, saliva, líquido cefalorraquidiano). A droga é excretada do corpo de um homem principalmente pelos rins.
Indicações para uso
A droga é prescrita após a confirmação do diagnóstico usando métodos de pesquisa de laboratório. Os comprimidos de Flucostat são utilizados nos seguintes casos:
- candidiase crica;
- balanite (inflamação do prepúcio do pênis);
- candidíase generalizada;
- prevenção de candidíase em homens durante o uso de quimioterapia;
- formas atípicas de candidíase em homens;
- sinais de aftas em crianças;
- recaída de sintomas de aftas em homens.
Dosagem e administração
As instruções de uso do medicamento dependem, em primeiro lugar, da forma do medicamento utilizado, da área da lesão com o fungo e da gravidade dos sintomas no homem. Além disso, é necessário ter em conta doenças concomitantes da pele e membranas mucosas, o uso atual de drogas locais e sistêmicas. A regra básica do uso de agentes antifúngicos para homens é a regularidade da internação.
Comprimidos Flucostat
A nomeação de uma determinada forma do medicamento depende da gravidade da doença e do tipo de lesão candidata. A medicação (em comprimidos) para fins terapêuticos e profiláticos é usada da seguinte forma:
- Para evitar a recorrência de meningite em homens com imunodeficiência: 200 mg / dia. durante um longo período (pelo menos 4-6 meses).
- Para outras infecções por Candida das membranas mucosas: 30-80 mg de Flucostat por dia durante duas a três semanas.
- Para evitar a ocorrência de aftas em homens com oncologia: 50-400 mg 1 p./day.
- Com micoses cutâneas (pés, região inguinal, etc.): 100 mg 1 pg / semana ou 50 mg 1 p / dia. por 2-3 semanas.
- Crianças a partir dos 6 anos com candidíase das membranas mucosas da cavidade oral 1 comprimido 2-3 r / Dia.
Cápsulas de Flucostat
O medicamento em cápsulas contém uma concentração mais baixa do componente ativo, por isso, é prescrito principalmente para prevenção. Um medicamento para o tratamento farmacológico de micoses de várias etiologias é feito da seguinte forma:
- Para a prevenção da recorrência de candidíase orofaríngea em pacientes com imunodeficiência: 150 mg 1 p.
- Com micoses endêmicas profundas: 200-400 mg / dia. por 11-12 meses (coccidioidomicose).

Solução
Flucostat para homens na forma de uma solução é prescrito para terapia medicamentosa de lesões fúngicas sistêmicas. O regime padrão para o uso da droga inclui: administrar a droga intravenosamente (iv) em um líquido ou gotejamento para candidiasis severo, disseminado no 1o dia - 150 ml de uma solução de flucostat, então - 70-100 ml / dia (durante 3-4 meses). Quando se transfere da administração iv para o uso de comprimidos ou cápsulas, não há necessidade de alterar a dose diária.
Instruções especiais
Em alguns casos, o uso de Flucostat é acompanhado por alterações tóxicas nas células do fígado, geralmente em homens com graves doenças sistêmicas concomitantes. O efeito hepatotóxico da principal substância ativa é reversível: seus sintomas pararam após o término da terapia medicamentosa. Se houver sinais clínicos de dano hepático grave (aumento da atividade enzimática, hepatomegalia), o medicamento deve ser descontinuado.
Homens com HIV são propensos a desenvolver reações cutâneas graves ao usar o Flucostat.Se um paciente que está recebendo terapia medicamentosa para uma infecção fúngica superficial, secura cutânea, coceira aparecer, o uso da droga também deve ser descontinuado. Uma erupção cutânea em homens com infecções fúngicas generalizadas indica intolerância aos componentes da droga. Precauções devem ser prescritas simultaneamente com antibióticos. Exclua o álcool.
Se a candidíase ou outras infecções fúngicas forem detectadas em um dos parceiros sexuais, a segunda deve ser testada para a detecção de microflora patogênica e iniciar medidas preventivas para evitar a exacerbação de aftas na pele ou nas membranas mucosas. Uma cápsula de 1 dia / dia é recomendada para evitar o desenvolvimento de sintomas de micose.
Efeitos colaterais
Se você exceder regularmente a dose prescrita do medicamento, os efeitos colaterais podem ocorrer. Com o uso prolongado de Flucostat na prática clínica, as seguintes conseqüências podem ocorrer:
- A partir do trato digestivo: uma mudança na percepção do paladar, náuseas, aumento de gases, vômitos, dor epigástrica, diarréia, sinais de insuficiência hepática (icterícia, hiperbilirrubinemia, aumento da concentração de enzimas hepáticas).
- Do sistema nervoso central: dor de cabeça, tontura.
- Reacções alérgicas: erupção cutânea, comichão, eritema, reacções anafilactóides.
- Outros: insuficiência renal, alopecia focal.

Contra-indicações
Com cautela, Flucostat deve ser usado para insuficiência cardíaca e outras patologias do sistema cardiovascular. Além disso, existem as seguintes contraindicações para o uso da droga:
- alta sensibilidade aos componentes do fármaco;
- crianças menores de 6 anos;
- distúrbios de condução do coração;
- insuficiência renal;
- perturbação do fígado.

Termos de venda e armazenamento
Flucostat deve ser armazenado em local seco e fresco, protegido da luz solar direta, inacessível a crianças pequenas e animais. O medicamento é dispensado de farmácias sem receita médica.
Análogos de Flucostat
Nos casos em que a droga não tem o efeito desejado ou causa efeitos colaterais, são prescritos medicamentos semelhantes em propriedades. Entre os análogos do Flucostat no mercado farmacêutico, os seguintes medicamentos podem ser distinguidos:
- Diflucan. Um agente antifúngico na forma de comprimidos, creme e pomadas destina-se à destruição de fungos do gênero Candida spp com danos locais à pele. Ele difere do Flucostat em uma alta concentração do componente ativo, então ele lida com as micoses mais rapidamente. No entanto, a droga geralmente causa efeitos colaterais.
- Fluconazol A medicação na forma de cápsulas, comprimidos e pomadas é um análogo de uma droga russa. A principal vantagem da droga é o seu preço (a partir de 35 rublos).

Preço Flucostat
O custo do Flucostat depende da forma de libertação do fármaco, do grau de purificação, da qualidade da substância activa principal e dos componentes auxiliares. O preço do medicamento pode ser afetado pela região e pela farmácia em que é vendido. Além disso, o custo do medicamento pode ser definido pelo fabricante. O preço aproximado da droga em Moscou:
|
Forma de liberação |
Nome da farmácia, Moscou |
Custo, rublos |
|
Comprimidos, 10 pcs |
Saúde da Montanha |
210 |
|
Cápsulas, 6 peças |
Fazenda Kalina |
156 |
|
Solução para administração intravenosa, 10 ampolas |
Kit de primeiros socorros |
220 |
Video
Comentários
Namorados, 35 anos velhos A fim de curar aftas na pele, o médico me receitou comprimidos de Flucostat e Pimafucin pomada. No segundo dia após o início da medicação, a coceira começou a diminuir e a descarga diminuiu, surgindo náusea e, no quinto dia, houve um ataque de vômito. Eu tive que recusar tomar pílulas, a doença foi curada apenas com pomada.
Gregory, 42 anos Após o parto, a esposa afoga-se quase todos os meses. Depois que os sintomas da doença começaram a aparecer em mim, o médico prescreveu Flucostat uma cápsula todos os dias para prevenção. Eu tenho tomado o remédio para o mês passado, não tenho notado quaisquer efeitos colaterais, a coceira e erupção nos genitais deixaram de incomodar.
Artemy, 46 anos Recebi conta-gotas com Flucostat quando estava sendo tratada em uma clínica de câncer. Os efeitos colaterais foram graves (náuseas, vômitos, sonolência constante), o médico prescreveu outra droga, mas piorou, então eles retornaram o primeiro medicamento. O médico explicou que isso se deve ao uso simultâneo da quimioterapia.

